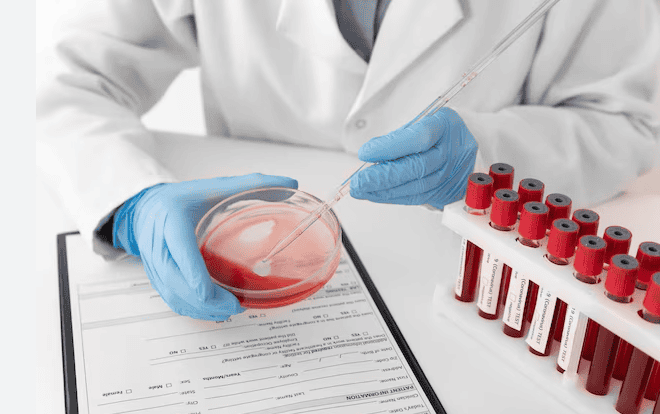

Les anàlisis de sang són estratègies que ens permeten mantenir cert control sobre com estar funcionant el nostre organisme. En el cas de l’esportista, s’ha de tenir en compte, i sempre individualment, que poden donar-nos dades que poden variar respecte a la població. Per això, hem d’aprendre a saber interpretar els valors de la teva analítica sanguínia si ets esportista
1. Sèrie roja: En un context de sobre entrenament els nivells d’hemoglobina poden baixar, ja que la realització de l’exercici dona lloc a un augment del volum sanguini, la qual cosa produeix una major dilució de les cèl·lules sanguínies en major volum de líquid. En situacions en les quals hi ha menys globus vermells (hematòcrit) i menys hemoglobina, però els nivells de ferritina estan alts, es coneix com a “anèmia de l’esportista”, se’n comú principalment en esportistes aeròbics d’alt rendiment, com corredors, nedadors o ciclistes.
Valor corpuscular mig (VCM) pot mantenir-se o disminuir-se, que, si va acompanyat d’un descens de l’hemoglobina durant un temps perllongat, derivarà en anèmies normo cròmiques o hipocròmiques.
2. Sèrie blanca: Es pot patir una disminució en el nombre de leucòcits i limfòcits en estat de dèficit de glucogen quan es fa una planificació d’entrenament molt exigent i existeix sobre entrenament. Els eosinòfils es poden disminuir en situacions en què hi ha un gran estrès i exercici físic intens, estats inflamatoris i defenses baixes.
Bioquímica dintre de l’analítica d’un esportista
1. Metabolisme de ferro
La ferratina pot incrementar-se en situacions de sobre entrenament, la qual cosa pot donar lloc a confusions, ja que es tracta d’un reactant de fase aguda. És a dir, és una molècula que augmenta en estats inflamatoris com és el cas de COVID-19. S’ha d’entendre, que no necessàriament aquest increment es deurà sempre a un estat patològic. L’índex de saturació de la transferrina és un biomarcador més específic i que indueix menys errades que la ferritina per valorar el nostre metabolisme del ferro. Els valors de transferrina estan lleugerament augmentats en esportistes a conseqüència d’una menor presència de ferro-
2. Glucosa
Per la regla general, els nivells de glucosa haurien sigut els mateixos en la població general que els esportistes, encara que hi ha excepcions. Els esportistes de resistència de llarga duració (marató, ciclisme, etc) solen tenir glucèmies més baixes com a conseqüència d’una major tolerància a la hipo glucèmia, per adaptació del seu cos a l’entrenament-.
3. Urea
La urea és un paràmetre que es pot veure incrementat en esportistes a arran de diverses causes amb deshidratació, sobre entrenament o ingesta elevada de proteïnes. Això significa que els esportistes poden tenir nivells més alts d’urea sense que això comporti un problema per la salut. Però, sempre es deu veure amb cautela, ja que l’increment d’alguna cosa lleuger, de forma que si és un increment és quelcom lleuger, de manera que si és un increment més brusc que s’hauria de buscar alguna altra cosa causa que el justifiqui.
4. Creatinina
Les persones que fan esport tenen nivells de creatinina més alts que aquells que no fan activitat física. Això és així perquè presenten major massa muscular (la creatinina es relaciona amb la creatina, i està com el múscul), prenen més proteïnes, poden estar suplementant-se amb creatina o el tipus d’exercici o el tipus d’exercici més proteïnes, poden estar suplementant-se amb creatina o el tipus d’exercici que realitzen i no significa necessàriament que estigui provocant un dany renal.
Això últim és important, ja que la creatinina sèrica és utilitzada per avaluar la funció renal, justificant que majors nivells en sang és com que el ronyó no funciona bé i no filtra aquest compost a la velocitat adequada. Es poden comparar altres paràmetres mitjançant altres proves diagnòstiques com és l’orina de 24 hores, la creatina en orina en 24 hores, etc., per valorar aquesta funció del ronyó. A més, un falliment renal normalment va acompanyat d’una presència de ions com potassi, magnesi i fòsfor en sang.
Bilirubina
En esportistes, l’augment de la bilirubina sol estar produït principalment per hemòlisis, a causa de la ruptura de glòbuls vermells per microtraumatismes com es pot donar en maratons. Aquests glòbuls vermells tenen hemoglobina, la qual cosa sal a la sang i es transformarà en bilirubina.
Sempre s’han d’analitzar altres possibles causes com anèmies hemolítiques, hepatitis, cirrosis, alcoholisme, etc.
Transaminases
Són enzims importants en processos d’anabolisme i catabolisme muscular- Aquests enzims no només es troben al fetge, per exemple, el GOT/AST es troba també en el múscul, per això en entrenaments molt exigents on hi ha trencament de fibres musculars aquesta es troba elevada en l’analítica de forma moderada. Una dieta rica en proteïnes pot elevar també les transaminases.
En patologies on es veuen incrementades les transaminases com hepatitis infeccioses, tumor hepatitis… l’elevació de transaminases com hepatitis infeccioses, tumors hepàtics… l’elevació de transaminases està d’un 500-1000% els valors normals, mentre que en esportistes no solen passar el 200%.
Creatina Quinasa (CK)
L’elevació d’aquest enzim el quelcom molt comú als esportistes, ja que es troba dins de les fibres musculars, de manera que el trencament d’aquestes durant una marató, una sessió intensa de CrossFit o entrenaments de futbol o d’altres esports molt forts, produeix l’alliberament de la mateixa sang. Si la seva elevació va molt més enllà dels límits normals podríem estar davant una rabdomiòlisi, que requereix hidratació, monitoratge i hospitalització. Aquests nivells haurien de corregir-se ràpidament després dels entrenaments.
Cortisol
El cortisol, coneguda com l’hormona de l’estrès, poden estar incrementada en els esportistes altament entrenats. Aquesta hormona està relacionada amb un augment de l’activitat catabòlica del nostre cos (pèrdua de massa muscular i glucogen), de manera que genera una sèrie de conseqüències negatives pel rendiment de l’esportista. Té un efecte contrari a la testosterona, ja que el seu nivell elevat es relaciona amb acumulació de greix i metabolisme més lent.
Per això, s’analitza la coeficient testosterona-cortisol, el qual deu ser elevat en esportistes per a aconseguir un increment del rendiment.
A l’hora de valorar una analítica, no només s’ha de tenir en compte els paràmetres i veure si estan dintre o no dels rangs normals, també s’ha de mirar el context i tot el que rodeja al citat individu. Els rangs normals estan establerts per la població general, que generalment és sedentària. Això fa que esportistes puguin tenir certs paràmetres fora dels citats rangs, però no es considera una cosa patològica.











